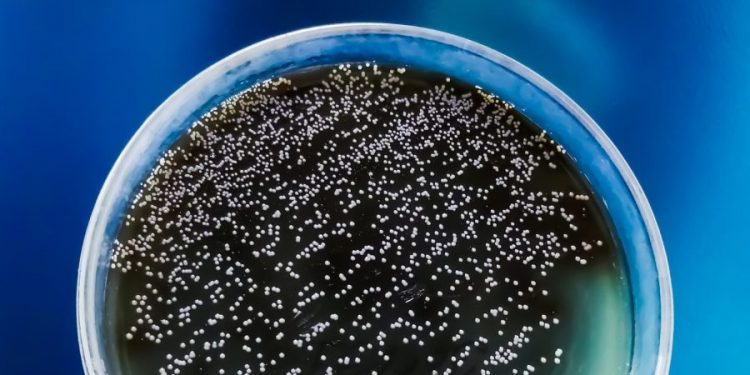
CDC warns of drug-resistant, deadly fungus: How is it spread?

(NEXSTAR) – The Centers for Disease Control and Prevention has identified Candida auris as an “urgent” threat as it spreads rapidly through U.S. hospitals, tripling in just three years. The fungus is spreading “at an alarming rate,” the CDC says, but how exactly is it spreading?
This fungus likely originated in a health care setting, explained Melissa Nolan, an assistant professor of epidemiology and biostatistics at the University of South Carolina. Counterintuitively, because hospitals are disinfected so frequently, they can be the birthplace of bacteria or fungus that are resistant to antimicrobial cleaning products and to treatments.
“If you think about the amount of cleaning that we do in the hospital versus what you do at home, it’s significantly greater in a hospital setting. So every time we’re spraying Clorox … that just creates the opportunity for more resistance,” Nolan explained. “Over time, those pathogens have been able to evolve and adapt to resistance.”
Candida auris is especially good at developing on surfaces, Nolan explained. Once it grows and populates in a hospital room, for example, it is most likely to infect a patient through a medical device, like a catheter or a PICC line that delivers medicine or fluids straight into the bloodstream.
Fungus an ‘urgent’ threat, already in these 28 states: CDC
“Imagine a patient that’s been in the hospital for two weeks, for example. Even though they’re cleaning those lines regularly, you still have the opportunity for this pathogen to get on that piece of plastic equipment and then get into your bloodstream,” said Nolan.
The fungus can also enter somebody’s system through ears or wounds, the Associated Press reports.
It could transmit by touch if someone touches an infected surface, then touches a piece of medical equipment that would enter a patient’s body. But people who are just visiting a loved one in the hospital or in a nursing home, for example, are not likely to become infected.
“It’s not highly transmissible the way that SARS-CoV-2 would be,” Nolan explained. “You really have to have that long extenuated exposure that has that direct access into your skin.”
However, Candida auris is still very dangerous for those who do catch it because it is resistant to anti-fungal drugs, making it hard to treat. An infection can cause severe illness or death.
“If you get infected with this pathogen that’s resistant to any treatment, there’s no treatment we can give you to help combat it. You’re all on your own,” Nolan said.
‘Ozempic face’: Doctors explain side effect of weight loss drugs
To make matters worse, the ones who are most likely to be infected with Candida auris – people with extended stays in the hospital – are likely already immunocompromised, so their systems may not be strong enough to fight off the infection.
The fungus was first detected in the United States in 2016, but it started spreading especially fast between 2021 and 2022. Since then, Candida auris has been found more than 8,000 times in at least 28 states, according to CDC tracking.
“The rapid rise and geographic spread of cases is concerning and emphasizes the need for continued surveillance, expanded lab capacity, quicker diagnostic tests, and adherence to proven infection prevention and control,” CDC epidemiologist Dr. Meghan Lyman said in a press release.
“It really highlights the fact that we need more antibiotics, more antifungals to come on the market,” Noland added. “For the most part – with the exception of the antivirus that came out for SARS-CoV-2 – we haven’t had a new antimicrobial treatment come out in over 30 years. And that’s a real concern for us.”